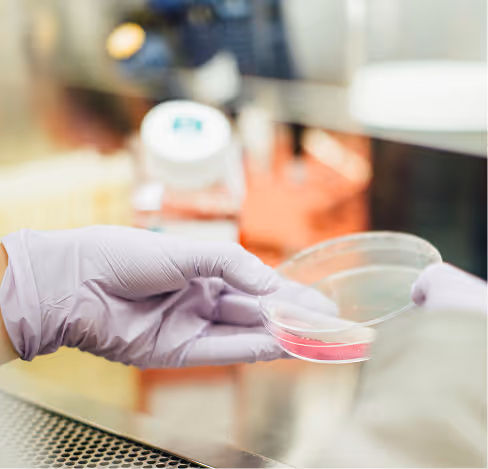

Leading Global Digital Commerce & AI-Powered Experience Solutions
We help growth-focused enterprises in Retail, Consumer Goods, Manufacturing, and Travel & Hospitality transform how they sell, serve, and grow, through AI-powered experiences that unite strategy, technology, and design.
We help growth-focused enterprises in Retail, Consumer Goods, Manufacturing, and Travel & Hospitality transform how they sell, serve, and grow through AI-powered experiences that unite strategy, technology, and design.
"Technology alone doesn't create transformation. It's about understanding the unique challenges our clients face, architecting solutions that evolve with their business, and obsessing over the outcomes that matter. That's the work we commit to every single day."
WHO WE ARE
We Don’t Just Implement Technology. We Architect Transformation That Endures.
Astound Digital is a global digital consultancy and systems integrator helping enterprises modernize their front office, connecting Sales, Service, Marketing, and Commerce into one intelligent ecosystem. We combine the precision of technical delivery with the creativity of experience design to help our clients create meaningful, measurable impact.
How We're Different
Boutique Partnership. Enterprise-Grade Impact
We deliver the hands-on attention of a boutique partner with the scale, depth, and delivery power of a global integrator.
engineers across optimal cost centers (US, Europe, LATAM, India)
global delivery centers
years of innovation
Solutions
We bring together deep expertise, AI innovation, and industry understanding to deliver results that last.
The Agentic Enterprise
The Future is Agentic
Astound is pioneering the rise of the Agentic Enterprise, where intelligent systems work alongside people to accelerate outcomes. Our Agentforce framework combines AI, automation, and Salesforce to turn every interaction into an intelligent, data-driven experience.
IMPACT
Proven Results. Real-World Outcomes.
a year in client revenue generated through Astound-built solutions
AI Agents deployed across enterprise ecosystems
successful projects
The Industries We Serve
Industry Expertise That Delivers
We focus where technology and customer experience meet, helping businesses evolve with insight, agility, and measurable results.

Manufacturing, Technology & A&D
Modernize complex service and sales ecosystems.

Travel, Transport & Hospitality
Deliver seamless, personalized journeys from booking to loyalty.

Retail & Consumer Goods
Connect digital commerce, marketing, and analytics for growth.
Med Tech & Life Sciences
Drive patient engagement and compliant digital innovation.
Our Mission & Vision
Building the Next Generation of Customer Engagement
Our mission is to help businesses transform the way they sell, serve, and grow by building connected customer experiences powered by AI, data, and automation.
Our vision is to be the most trusted partner for front-office transformation, creating experiences that are unified, intelligent, and future-ready.

Ready to Build What’s Next?
Whether you’re modernizing your CRM, scaling B2B commerce, or embedding AI across your enterprise, Astound Digital helps you move from strategy to measurable success.










